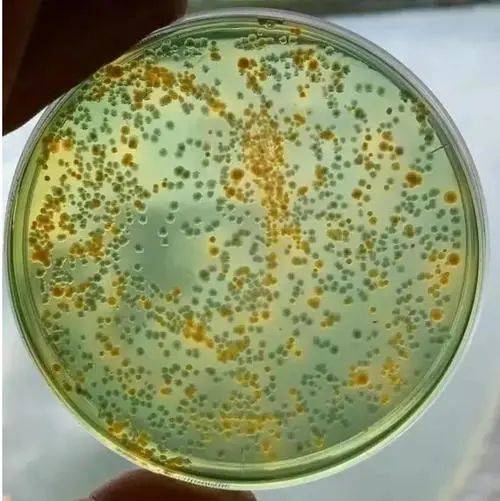
原创天天讲弧菌但你真的了解它吗弧菌越杀越多可能与它有关

杀弧菌

噬菌蛭弧菌冻干粉弧克 水产养殖 杀弧菌克星鱼虾蟹塘调水 净水
图片尺寸750x750
说说怎么消灭弧菌 包杀产品(以检测为依据)
图片尺寸993x1191
阴雨天对虾弧菌灭杀是重点
图片尺寸608x553
弧菌速消 500克水产鱼药对虾虾蟹杀灭弧菌改善底质抗应激增强食欲
图片尺寸800x800
噬菌蛭弧菌冻干粉噬弧菌龙虾弧菌速净小龙虾肠炎弧菌克星杀弧菌
图片尺寸800x800
医生提醒大家,创伤弧菌普遍生存于海洋中,5到10月是高发期.
图片尺寸440x440
原创天天讲弧菌但你真的了解它吗弧菌越杀越多可能与它有关
图片尺寸500x501
某对虾海水养殖池塘使用前每0.1 毫升海水总弧菌数量
图片尺寸526x283
弧菌都严重超标,建议使用菌美6号这种无任何刺激的生物制剂来杀弧菌
图片尺寸928x550
越杀越多!弧菌,一定要赶尽杀绝吗?_养殖_对虾_水体
图片尺寸782x562
据了解,高危人群感染创伤弧菌后,48小时的死亡率高达50%,总体死亡率达
图片尺寸600x376
周口市生物杀毒消毒剂以客为尊弧菌
图片尺寸451x440
关于南美白对虾弧菌超标问题
图片尺寸2000x2667
弧菌清 蛭弧菌冻干粉 鱼虾蟹杀弧菌 优化水环境 增强免疫力 渔药
图片尺寸800x800
水产养殖弧菌防治三步走轻松解决
图片尺寸960x528
弧菌克星 南美白对虾养殖杀弧菌 吞噬弧菌 虾空肠空胃无活力偷死
图片尺寸800x800
技术| 五六月份,弧菌开始在对虾塘活动了,这份弧菌防控方案请拿好!
图片尺寸409x520
弧菌克星速消生物杀弧菌噬菌蛭控制弧菌鱼虾蟹塘水产养殖除有害菌
图片尺寸800x800
其它 七日养虾 助您养好小龙虾 写美篇详解七日养虾 一消(杀弧菌)
图片尺寸964x722
噬菌蛭弧菌冻干粉水产养殖杀弧菌弧菌克星鱼虾蟹塘调水净水弧菌清
图片尺寸300x300